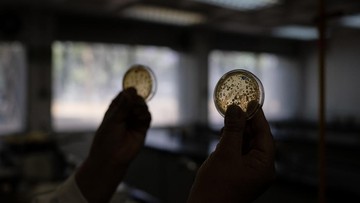

Mendag Budi Santoso mengancam akan mencabut izin usaha perusahaan yang terbukti mengimpor barang secara ilegal atau tidak sesuai ketentuan.
Read MoreOtoritas Jasa Keuangan (OJK) mengatakan akan menyambut baik jika PT Asuransi Tugu Pratama Tbk. (TUGU) alias Tugu Insurance mengakuisisi PertaLife.
Read MoreIlmuwan di Meksiko mengembangkan jenis tortilla baru yang dapat bertahan selama beberapa minggu tanpa harus masuk kulkas. Ini ceritanya.
Read MoreProgram "Spectacular Surprise" berjalan pada 12 Mei-12 Agustus 2025, dengan pengundian yang akan diadakan pada 31 Agustus di Mall Artha Gading, Jakarta Utara.
Read MoreMeski Indonesia punya penduduk terbanyak di Asia Tenggara, ternyata negara ini bukanlah negara terkaya di ASEAN.
Read MoreSitus web PeduliLindungi.id telah pulih setelah Kementerian Komunikasi dan Digital melakukan take down.
Read MoreRupiah Menguat, Dolar AS Jatuh ke Level Rp 16.200-an
Read MorePT Pertamina Hulu Energi (PHE) sebagai Subholding Upstream Pertamina menyepakati 10 Perjanjian Jual Beli Gas (PJBG) demi mendorong transisi ke energi bersih.
Read MoreNanti ketika produksi stabil dan cadangan pangan pemerintah cukup atau relatif lebih aman, pemerintah seharusnya juga bisa mengekspor beras reguler.
Read MoreBeberapa emiten akan menggelar Rapat Umum Pemegang Saham Tahunan (RUPST) pada 12 Juni mendatang.
Read More